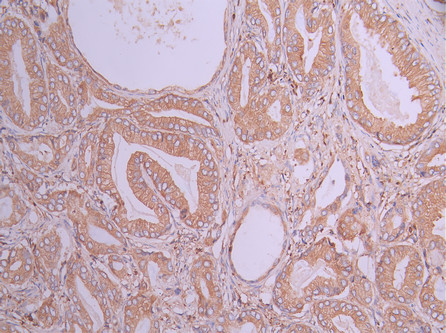

-
中文名稱:CAP1 Recombinant Monoclonal Antibody
-
貨號:CSB-RA791902A0HU
-
規格:¥1320
-
圖片:
-
Western Blot
Positive WB detected in: THP-1 whole cell lysate(30μg), A431 whole cell lysate(30μg), U-251MG whole cell lysate(30μg), HeLa whole cell lysate(30μg), HT-29 whole cell lysate(30μg), PC-3 whole cell lysate(30μg), MCF-7 whole cell lysate(30μg), K562 whole cell lysate(30μg)
All lanes: CAP1 antibody at 1:1000
Secondary
Goat polyclonal to rabbit IgG at 1/40000 dilution
Predicted band size: 52 kDa
Observed band size: 55 kDa
Exposure time:30s -
IHC image of CSB-RA791902A0HU diluted at 1:100 and staining in paraffin-embedded human prostate cancer performed on a Leica BondTM system. After dewaxing and hydration, antigen retrieval was mediated by high pressure in a citrate buffer (pH 6.0). Section was blocked with 10% normal goat serum 30min at RT. Then primary antibody (1% BSA) was incubated at 4°C overnight. The primary is detected by a Goat anti-rabbit polymer IgG labeled by HRP and visualized using 0.05% DAB.
-
-
其他:
產品詳情
-
Uniprot No.:
-
基因名:
-
別名:Adenylyl cyclase-associated protein 1 (CAP 1), CAP1, CAP
-
反應種屬:Human
-
免疫原:A synthesized peptide from human CAP1 protein
-
免疫原種屬:Homo sapiens (Human)
-
標記方式:Non-conjugated
-
克隆類型:Monoclonal
-
抗體亞型:Rabbit IgG
-
純化方式:Affinity-chromatography
-
克隆號:10F9
-
濃度:It differs from different batches. Please contact us to confirm it.
-
保存緩沖液:Preservative: 0.03% Proclin 300
Constituents: 50% Glycerol, 0.01M PBS, PH 7.4 -
產品提供形式:Liquid
-
應用范圍:ELISA, WB, IHC
-
推薦稀釋比:
Application Recommended Dilution WB 1:500-1:2000 IHC 1:50-1:200 -
Protocols:
-
儲存條件:Upon receipt, store at -20°C or -80°C. Avoid repeated freeze.
-
貨期:Basically, we can dispatch the products out in 1-3 working days after receiving your orders. Delivery time maybe differs from different purchasing way or location, please kindly consult your local distributors for specific delivery time.
-
用途:For Research Use Only. Not for use in diagnostic or therapeutic procedures.
相關產品
靶點詳情
-
功能:Directly regulates filament dynamics and has been implicated in a number of complex developmental and morphological processes, including mRNA localization and the establishment of cell polarity.
-
基因功能參考文獻:
- RETN and CAP1 polymorphisms and gene expression may be potential biomarkers for breast cancer risk PMID: 29641286
- Significant up-regulation of PBMCs CAP1, CD36 mRNA and plasma resistin found in significant coronary artery disease, as well as in nonsignificant coronary artery disease compared to control group, indicates that resistin could be able to exert its effects stronger on cells with up-regulated CAP1 mRNA thus contributing atherosclerosis development. PMID: 28707728
- REVIEW: summarizes information available to date about the structural organization, regulation of functional activity of adenylyl cyclase-associated protein 1 (CAP1), and its participation in cellular processes PMID: 29534668
- Results identify a role for CAP1 in regulating proliferative transformation of cancer cells, with ERK signaling playing pivotal roles in mediating both cell functions. PMID: 27173014
- CAP1 expression is markedly increased in human glioma and that downregulation of CAP1 in tumors may serve as a treatment for glioma patients. PMID: 27432289
- our results indicated that CAP1 participated in the molecular pathological process of glioma PMID: 26810579
- a high expression of CAP1 is involved in the pathogenesis of EOC, and that the downregulation of CAP1 in tumor cells may be a therapeutic target for the treatment of patients with EOC. PMID: 25652936
- This study demonstrated an inverse relationship between CAP1 and MMP-9 expression, high expression of MMP-9 and low expression of CAP1 in those with chronic obstructive pulmonary disease compared with the non-chronic obstructive pulmonary disease group. PMID: 25332229
- CAP1 is involved in the brain metastasis in non-small cell lung cancer.CAP1 overexpression is associated with poor prognosis in non-small cell lung cancer patients. PMID: 25371324
- Overexpression of CAP1 in monocytes enhanced the resistin-induced increased activity of the cAMP-dependent signaling. PMID: 24606903
- results indicate that upregulated expression of CAP1 might contribute heavily to the metastasis of hepatocellular carcinoma. PMID: 24359721
- Overexpression of CAP1 is associated with breast carcinoma. PMID: 24522810
- CAP1 might be a potential molecular targeted therapy for surgery and immune treatment. PMID: 24509166
- overexpression of CAP1 in lung cancer cells, particularly at the metastatic stage, may have significant clinical implications as a diagnostic/prognostic factor for lung cancer. PMID: 23842884
- CAP1 depletion also led to changes in cofilin phosphorylation and localization as well as activation of focal adhesion kinase (FAK) and enhanced cell spreading. PMID: 23737525
- Findings suggest that CAP1 (cyclase-associated protein 1) is involved in the metastasis of esophageal squamous cell carcinoma, and increased expression may indicate a poor prognosis. PMID: 23904342
- plays a key role in speeding up the turnover of actin filaments by effectively recycling cofilin and actin and through its effect on both ends of actin filament PMID: 11950878
- Based on an analysis of 1075 beta-thalassemia alleles the CAP+1 (A-->C) mutation constituted 3.2% of north Indians. PMID: 17900295
- The high turnover rate of CAP1 by MMP-9, comparable to that of gelatin as the natural extracellular substrate of this enzyme, may be critical to prevent pathological conditions associated with considerable cytolysis. PMID: 18671965
- These studies suggest that CAP1 provides a direct link from the actin cytoskeleton to the mitochondria by functioning as an actin shuttle. PMID: 18716285
- The overexpression of CAP1 in pancreatic cancers is demonstrated and the involvement of CAP1 in the aggressive behavior of pancreatic cancer cells is suggested. PMID: 19188911
顯示更多
收起更多
-
亞細胞定位:Cell membrane; Peripheral membrane protein.
-
蛋白家族:CAP family
-
數據庫鏈接:
Most popular with customers
-
-
YWHAB Recombinant Monoclonal Antibody
Applications: ELISA, WB, IHC, IF, FC
Species Reactivity: Human, Mouse, Rat
-
Phospho-YAP1 (S127) Recombinant Monoclonal Antibody
Applications: ELISA, WB, IHC
Species Reactivity: Human
-
-
-
-
-